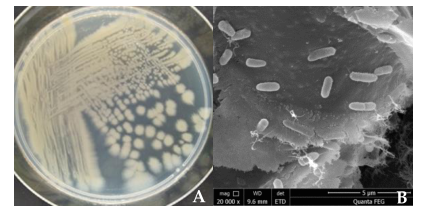
image.png

2021-11-09

期刊:《Pathogens》
影响因子:3.492
2021年11月2日,派森诺与上海中医药大学黎万奎老师课题组,在微生物基因组领域的《Pathogens》发表研究成果!该研究从藏红花的根际土壤中分离得到了铜绿假单胞菌YY322,通过拮抗实验发现该菌株对藏红花的病原菌具有较强的拮抗,全基因组测序揭示了该菌株在植物生长促进和生物防治机制中的作用,为铜铝假单胞菌作为植物促生菌用于藏红花生产提供了证据,为微生物肥料的开发利用奠定了理论基础。
研究背景
藏红花是中国一种重要的药用植物,具有活血化瘀、凉血解毒、缓解抑郁、镇定神经的功效。由于藏红花产量低、价值高、价格昂贵、被称为“红色黄金”。目前上海崇明岛可以广泛种植藏红花,但由于长期连作等因素,许多球茎已经腐烂,导致藏红花产量和质量下降。有研究表明,植物根际土壤环境独特,大量微生物聚集在该区域,为植物的生长发挥着重要作用。从根据土壤中目前已经分离除大量具有增长植物养分吸收和免疫功能的植物促生菌(PGPR),其中假单胞菌是一种广泛分布于自然界的专性需氧革兰氏阴性杆状细菌,其生长迅速,能适应自然环境,而且还能分泌一系列代谢物,有效地拮抗植物病原体的发生和发展,帮助植物吸收和利用营养物质。本研究从藏红花根际土壤中分离得到了85株细菌,其中YY322菌株对藏红花5种病原菌具有较好的拮抗作用,结合生理生化试验和分子生物学鉴定,确定该菌为铜绿假单胞菌。通过全基因组测序分析,进一步探索其拮抗和促生长机制。
研究材料与方法
1.实验材料:藏红花根际土壤中分离得到的通路假单胞菌YY322分离株
2.测序平台:Illumina Novaseq+Pacbio
3.分析内容:细菌完成图测序、16S进化树构建、次级代谢产物基因簇分析、菌株形态和生理生化实验等。
研究结果
1.拮抗细菌的分离和筛选
从藏红花根际土壤中分离得到85株细菌,经过多次筛选,菌株YY322的拮抗效果最好,对尖孢镰刀菌(F.oxysporum)、茄病镰刀菌(F.solani)、柠檬黄青霉(P.citreosulfuratum,)、橘青霉(P.citrinum)和唐菖蒲菌(S.gladioli)的抑制率分别为73.17%、62.20%、23.16%49.17%和79.76%。实验发现不仅病原菌的生长受到了明显的抑制,菌株YY322的形态特征与正常状态相比也发生了明显的变化,这表明该菌株可能产生了一些未知的抗真菌物质。

图1:菌株YY322对PDA培养基上培养1 ~ 2周的5种病原菌的拮抗作用
2.菌株YY322的SEM和TEM相互作用研究
SEM显示,在菌株YY322作用下,镰刀菌菌丝和分生孢子与对照组相比发生了显著变化。对照组菌丝圆润饱满、形态结构完整、表面光滑、厚度均匀;分生孢子正常纺锤形,中等大小、显示出良好的生长状态。菌株YY322侵染的F.oxysporum菌丝大量断裂、菌丝表面凹凸不平,切分严重,顶端发育异常,分生孢子畸形。菌株YY322侵染F.solani后,菌丝严重受损,表面收缩,内容物渗漏。

图2:扫描电镜下菌丝和分生孢子形态变化的观察
TEM显示,对照组菌丝分布均匀,菌丝呈规则圆形,菌丝边界清晰。细胞壁和细胞膜保持完整致密,细胞质分布均匀,维持正常生长状态。与对照组相比,菌株YY322作用下镰刀菌的内部结构受到严重破坏。菌株YY322侵染的F.oxysporum菌丝细胞壁破裂,导致内容物外泄,液泡数量减少、体积增大,胞浆浑浊、混乱。侵染的F.solani表现出大量未成熟分生孢子聚集在一起,菌丝切片形状异常。细胞壁增厚,胞浆混合呈黑色,液泡几乎消失。

图3:透射电镜(TEM)下观察菌丝内部结构的变化
3.菌株YY322挥发性有机物(VOCs)对菌丝生长的抑制作用
在菌株YY322的培养过程中发现该菌株可以产生一种特殊的气味,故测试了其VOCs的抗真菌作用,结果表明它对F.oxysporum和F.solani有明显的抑制作用,抑制率分别为90.24%和89.02%。有趣的是,仍然可以观察到两种病原体的少量菌丝扩散到整个平板(图4)。

图4:VOCs的抗真菌活性:(A)尖孢镰刀菌;(B)番茄镰刀菌(1)对照组;(2)实验组。
4.菌株YY322的形态鉴定和生理生化实验
菌株YY322在30℃下孵育24h后LB培养基上的单个菌落几乎是圆形的,相对扁平,浅黄绿色,不光滑,不透明,边缘不规则(图5A)。SEM观察到菌株YY322呈棒状,大小约为0.5µm × 2µm(图5B)。随后,菌株YY322根据其16S rDNA序列系统发育树(图6)鉴定为P. aeruginosa,保存在GenBank中,登录号为MZ026485,最后通过生理生化试验确认菌株YY322为P. aeruginosa。
图5:YY322菌株的形态:(A)菌落形态;(B)微观形态

图6:YY322菌株16S rDNA序列系统发育树
表1:菌株YY322的形态、生化、植物促生和拮抗活性

对菌株YY322进行生理生化实验分析,结果发现该菌株:1.表现出较强的蛋白酶活性和较弱的葡聚糖酶活性,但纤维素酶和几丁质酶活性缺乏;2.能固定氮,溶解有机磷酸盐和无机磷酸盐,产生铁载体和NH3,但不溶解钾,不产生IAA和ACC脱氨酶。
5.菌株YY322的全基因组测序
全基因组测序得到一条环状的、大小为6382345bp、GC含量为66.47%的染色体,预测得到了5809个编码基因、64个tRNA、12个rRNA、75个其他ncRNA和7个CRISPR结构。在GO、KEGG、eggNOG数据库分别预测到了4377、3192和5254个编码基因。GO注释得到的途径包括生物过程、分子功能、细胞、生物合成过程、细胞氮化合物代谢过程、细胞成分和离子结合。eggNOG分类注释显示,90.45%的蛋白编码基因可以被注释到,有555个基因未被注释到。其中转录基因最为丰富,有455个,占7.83%;其次是调节氨基酸运输和代谢的基因有436个,占7.51%。KEGG通路的8种分类中,其中蛋白家族:信号传导和细胞过程、遗传信息处理、代谢)中包含的基因数量最多,其次是代谢相关的通路(氨基酸和碳水化合物代谢)。

图7:菌株YY322的全基因组圈图

图8:各个数据库的注释结果
CAZymes分析表明糖基转移酶(GTs;40个基因)家族是主要分类,其次是碳水化合物酯酶(CEs;34个基因)和糖苷水解酶(GHs;33个基因)。antiSMASH分析结果表明,菌株YY322编码15个次级代谢产物生物合成基因簇(BGCs),包括4个NRPS、2个NRPS-like、2个RiPP、2个phenazine、一个T1PKS、一个T3PKS、一个氧化还原辅助因子、一个硫肽类和一个倍他内酯。其中3个与编码coelibactin、绿脓菌青素和l -2-氨基-4-甲氧基-反式-3-丁烯酸的基因具有100%的相似性(表2)
表2:菌株YY322的次级代谢产物基因簇预测结构

研究结论
1.研究发现通路假单胞菌可以作为藏红花病原菌的生防剂,初步试验表明其具有PGPR性状;
2.本研究首次报道了铜绿假单胞菌对 P. citreosulfuratum, P. citrinum和S. gladioli具有拮抗作用。
综上所述,认为菌株YY322可以发展成为藏红花微生物肥料,后续会继续通过室内和田间试验进一步验证菌株YY322的拮抗和PGPR作用。
本研究的denovo测序和部分数据分析由上海派森诺生物科技有限公司完成。